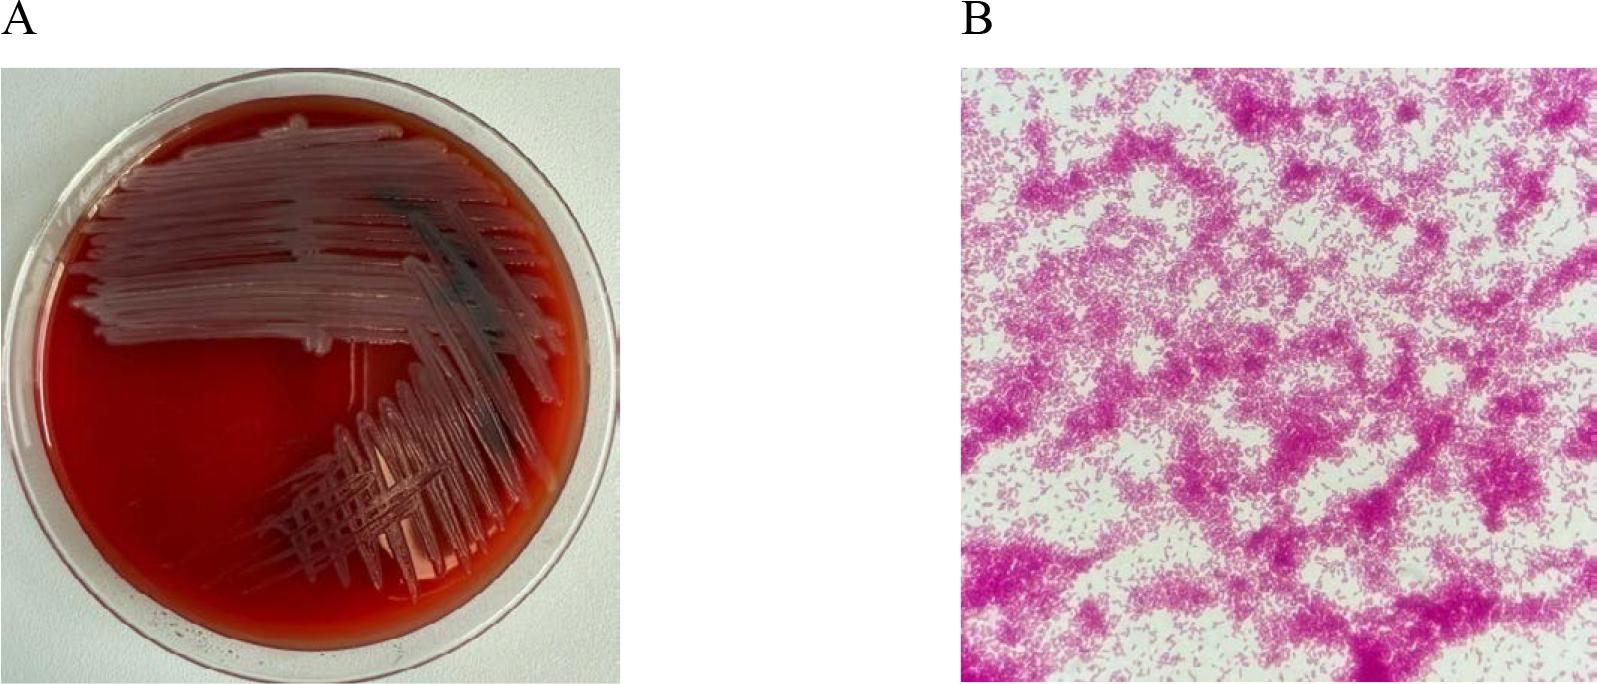
In vitro cultures of Pseudomonas aeruginosa on Columbia Agar with 5% sheep blood (A) and a Gram-stained preparation of Pseudomonas aeruginosa viewed under a light microscope (magnification x1000). Source: own elaboration.

Figure 1.

Figure 2.

Figure 3.

Figure 4.

Figure 5.

Figure 6.

Figure 7.

Figure 8.

Figure 9.
Classification of β-lactamases according to Ambler_
| Class | Active site | Type of β-lactamases | Substrates |
|---|---|---|---|
| A | Serine | Penicillinases | Penicillins, first-generation cephalosporins |
| ESBL | Penicillins, first, second, third, and fourth-generation cephalosporins, aztreonam | ||
| Carbapenemases | Penicillins, first, second, third, and fourth-generation cephalosporins, carbapenems, monobactams | ||
| B | Zn++ | Metallo-β-lactamases | β-lactams except monobactams |
| C | Serine | AmpC cephalosporinases | Penicillins, cephalosporins (except for fourth-generation cephalosporins and carbapenems) |
| D | Serine | Oxacillinases | Penicillins (including isoxazolyl penicillins), first and second-generation cephalosporins |
| Carbapenemases | Carbapenems |